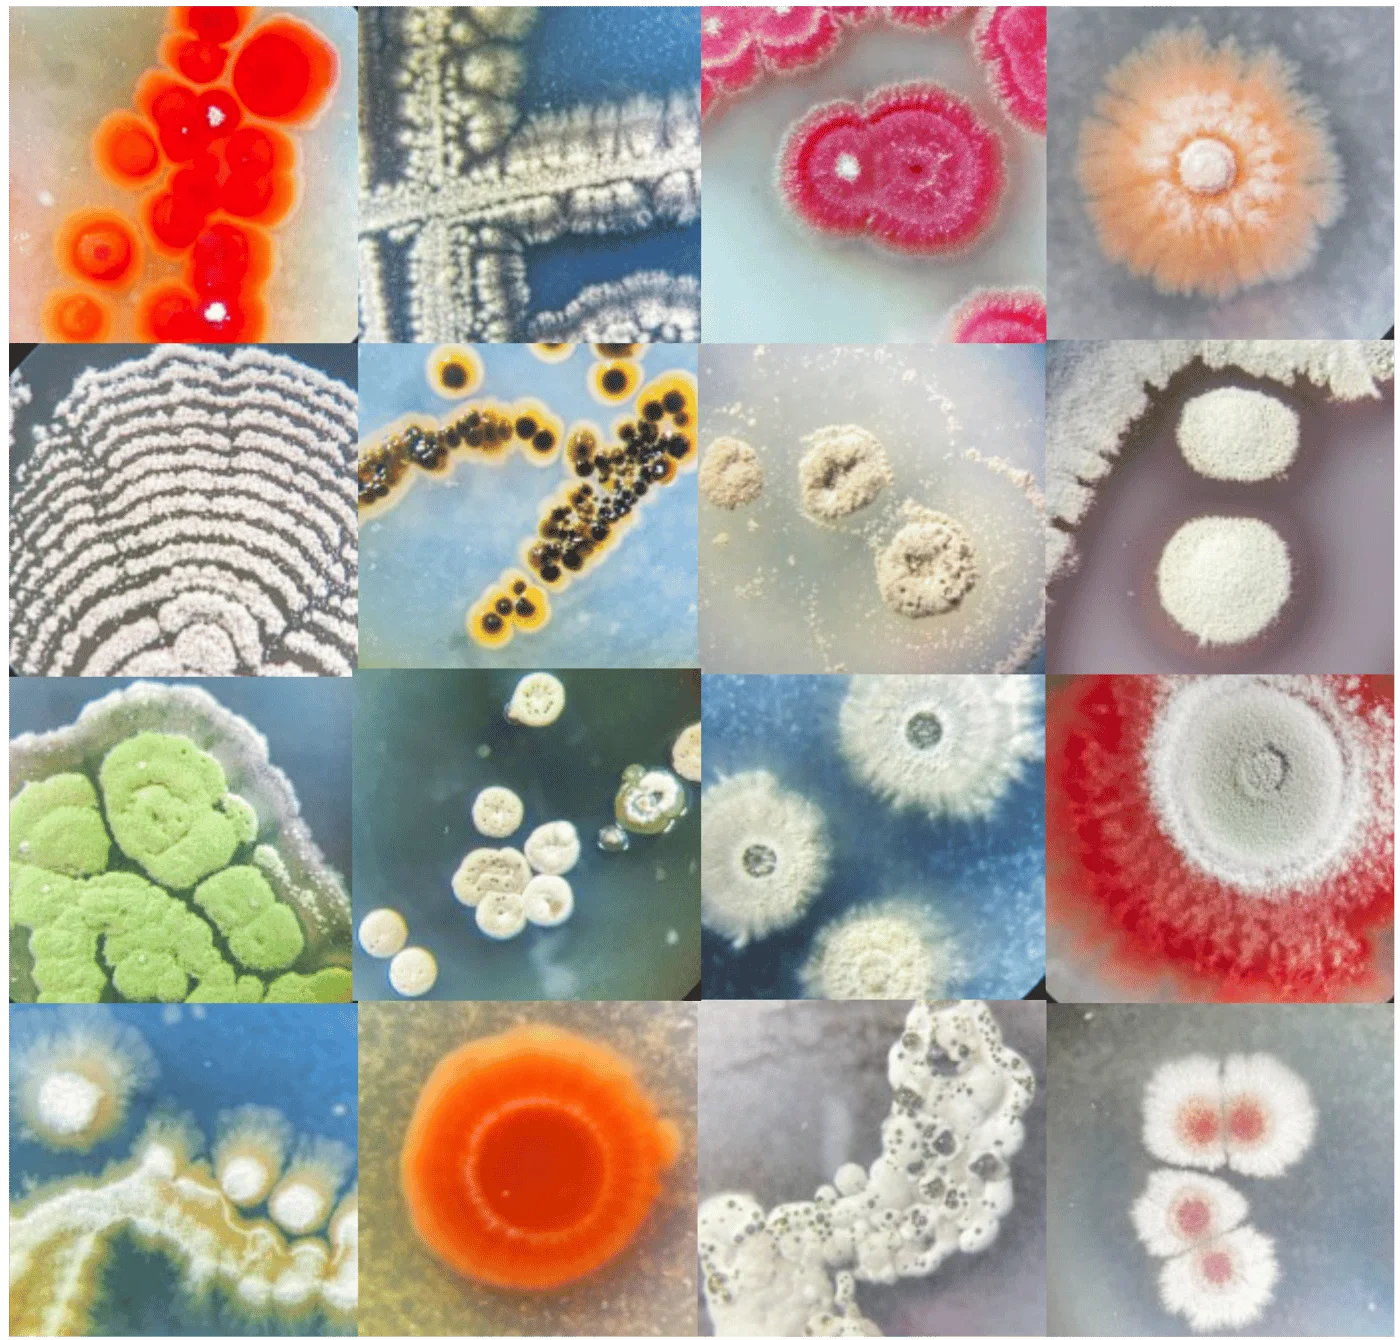
Actinobactérias marinhas: tesouros microbianos dos oceanos para aplicações biotecnológicas

Actinobactérias marinhas: tesouros microbianos dos oceanos para aplicações biotecnológicas Com Fátima Carvalho
- Local: Serralves, R. D. João de Castro, 210
- Data: 19 de Maio
- Horário: 11:00
O mar guarda um enorme potencial biotecnológico, com grande parte deste tesouro escondido nas actinobactérias que o povoam. Explorar este potencial pode ser a chave para a descoberta de novas moléculas.
A natureza é uma fonte constante de inovação, oferecendo uma infinidade de compostos naturais com potencial para revolucionar diversos setores da nossa sociedade. No que diz respeito à produção destes compostos, um grupo de microrganismos, as actinobactérias, destaca-se pela sua enorme capacidade de síntese de moléculas bioativas, com aplicações potenciais nos setores farmacêutico, cosmético, industrial, entre outros. Surpreendentemente, cerca de dois terços de todos os antibióticos atualmente utilizados, assim como uma vasta gama de compostos anticancerígenos, imunossupressores, herbicidas e antivirais são produzidos por estes microrganismos.
No esforço contínuo para a descoberta de novas moléculas bioativas, o mar surge como uma fonte promissora, graças à sua imensa biodiversidade microbiana ainda por explorar.
Nesta conversa, iremos explorar o fascinante mundo das actinobactérias marinhas, focando na sua diversidade e distribuição nos ambientes marinhos, assim como no seu vasto potencial para a descoberta de moléculas bioativas, fundamentais para o desenvolvimento de medicamentos e outras aplicações importantes.